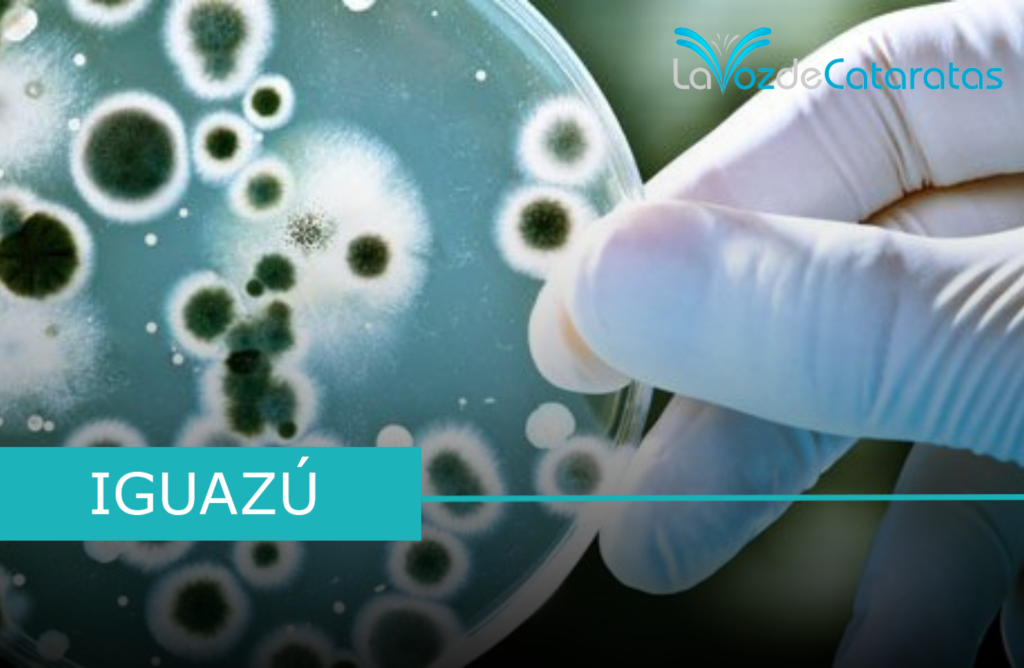

Iguazú (LaVozDeCataratas) Como antesala a la 10º edición del Congreso Argentino de Parasitología (X CAP) que se realizará en la ciudad de Iguazú, del 7 al 9 de mayo de 2025, el lunes 5 de mayo, profesionales y especialistas organizarán una jornada especial dividida en dos momentos: por la mañana, brindarán charlas educativas en escuelas locales, y por la tarde, se realizará una Feria «Conociendo a los parásitos».
En tanto la Dirección de Zoonosis de la Municipalidad se sumará para trabajar en conjunto en la Plaza San Martín , entre los temas que se abordarán se encuentran las zoonosis y la transmisión de parásitos a las personas, con el objetivo de fomentar la prevención y el cuidado de la salud. Distintos stands ofrecerán información, materiales educativos y espacios de consulta, en un formato didáctico y accesible para todas las edades.
La propuesta busca acercar la ciencia a la comunidad, promoviendo el conocimiento sobre las enfermedades parasitarias y su impacto en la salud pública.